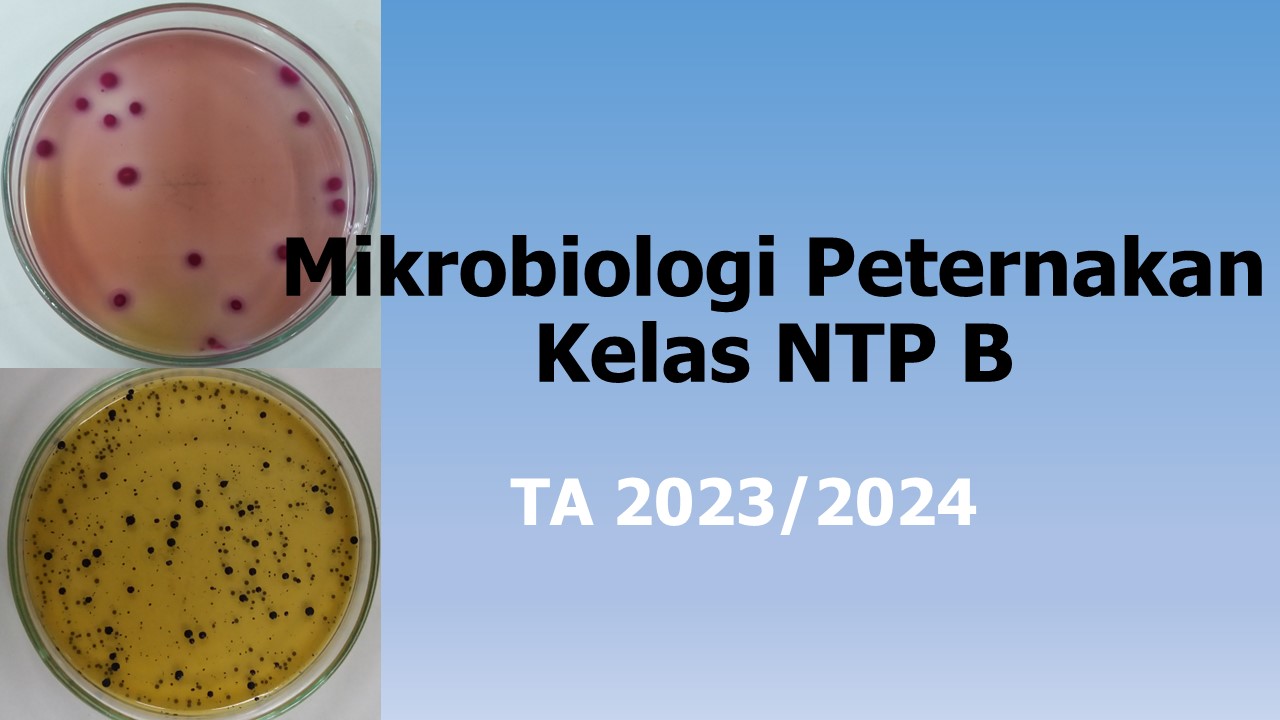
Mikrobiologi Peternakan Kelas NTP B 2023/2024

Enrolment options
Mikrobiologi Peternakan adalah mata kuliah wajib semester dua di Program Studi Nutrisi dan Teknologi Pakan Ternak Fakultas Pertanian Universitas Lampung.
- Teacher: Muhammad Mirandy Pratama Sirat
- Teacher: Veronica Wanniatie
- Enrolled students: 32